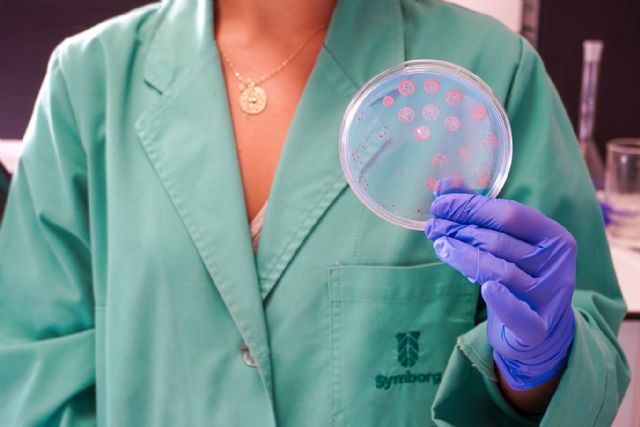
Corteva Agriscience firma un acuerdo para adquirir la española Symborg - 1, Foto 1

La adquisición forma parte de la ejecución de la estrategia para acelerar la visión de Corteva Agriscience de convertirse en líder de los productos biológicos, ofreciendo opciones naturales que ayuden a los agricultores a satisfacer las cambiantes expectativas del mercado
Symborg, líder en productos biológicos para la agricultura, mantiene su estructura, conservando su sede central en Murcia, sus filiales en Estados Unidos, México, Perú, Chile, Brasil, Francia, Turquía, China y Australia, así como a su equipo humano
Corteva, Inc. (NYSE: CTVA) y Symborg han anunciado hoy que Corteva ha firmado un acuerdo definitivo para adquirir Symborg, compañía experta en tecnologías microbiológicas con sede en Murcia. Respetada en toda la industria de sus productos biológicos, Symborg posee una cartera diversificada, un proyecto emergente de control biológico y una base de empleados cualificados con sólidos conocimientos técnicos y experiencia en la generación de demanda.
"La adquisición de Symborg es un paso importante en la estrategia de Corteva para acelerar el desarrollo de una cartera de productos biológicos de primera clase, como parte de las soluciones integradas que ofrecemos a nuestros clientes", afirma Robert King, vicepresidente Ejecutivo de la Unidad de Negocio de Protección de Cultivos de Corteva Agriscience. "En los últimos tres años, Corteva ha establecido acuerdos de licencia y distribución con las principales empresas de productos biológicos, seleccionadas tras evaluar las tecnologías y demostrar la aceptación de los clientes. Esta adquisición muestra la progresión de Corteva para seguir estableciéndose como líder tecnológico en este segmento de rápido crecimiento".
Corteva colaboró por primera vez con Symborg para ampliar y llevar a los agricultores Utrisha™ N y BlueN™, optimizador de la eficiencia de nutrientes, como parte de un acuerdo de distribución entre las dos empresas. El innovador bioestimulante de origen natural permite a las plantas fijar el nitrógeno del aire y ponerlo a disposición de la planta, proporcionando una fuente de nitrógeno alternativa y suplementaria y reduciendo potencialmente la emisión de gases de efecto invernadero por el uso de fertilizantes.
Esta operación continúa con el compromiso de Corteva de construir una cartera más diferenciada y sosteniblemente ventajosa que proporcione soluciones rentables para los agricultores. Corteva aprovechará las sinergias entre organizaciones para ampliar las soluciones actuales de Symborg, así como los nuevos productos en desarrollo.
"El objetivo de Symborg siempre ha sido apoyar a los agricultores de todo el mundo con soluciones biológicas de vanguardia" explica Jesús Juárez, socio fundador y CEO de Symborg. "Esta motivación, junto con un equipo altamente cualificado, nos ha llevado a convertirnos en un actor clave para la agricultura sostenible. La integración con Corteva se convierte en una oportunidad para reforzar nuestro impacto en el campo, ayudando a los agricultores a afrontar los retos actuales y futuros. Y más allá, una oportunidad para dar respuesta a una sociedad que demanda alimentos seguros y sostenibles. Symborg y Corteva comparten valores y visión de mercado, convirtiéndose en una gran unión para diseñar el futuro de la agricultura".
El cierre de la adquisición está sujeto a las condiciones habituales de cierre. Tras el cierre, las instalaciones de Symborg en Murcia, España, y las filiales en Estados Unidos, México, Perú, Chile, Brasil, Francia, Turquía, China y Australia se convertirán en elementos clave de la cartera de productos biológicos de Corteva.
Los términos y condiciones financieras del acuerdo no fueron revelados.
AdvisorsRoth Capital Partners, LLC actuó como asesor financiero exclusivo de Symborg, DelSaz Abogados y D. Javier Maceira Suárez actuaron como asesores legales de Symborg y Tarabini-Castellani como asesor de los socios fundadores de Symborg.